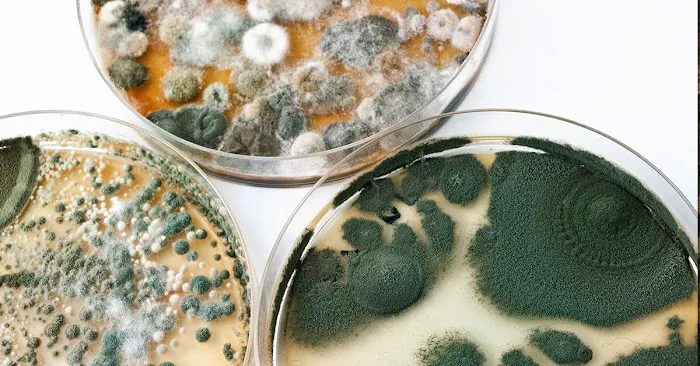
Prime Picture 1
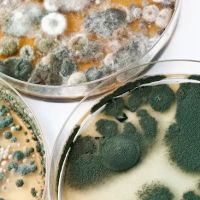
Prime ico

Prime Photos

Prime Introduce
For homeowners and businesses across Southern Maryland, particularly in the Waldorf area, dealing with unexpected property damage—whether from a burst pipe, a major storm, or a sudden fire—requires immediate, professional intervention. **Prime Restoration** is a top-tier **Water Damage Restoration Service** and comprehensive general contractor specializing in bringing properties back to life after a disaster. They are a single-source solution, meaning they handle everything from the initial emergency mitigation to the final reconstruction and remodeling.
Prime understands the stress and urgency involved in these situations. Their core mission is to restore normalcy, not just property. This dedication is evident in their rapid-response capabilities, expert handling of complex issues like **Black Mold Removal** and **Asbestos Removal**, and their commitment to achieving **Full Restoration To Pre Disaster Conditions**. They serve as the reliable, professional bridge between a stressful incident and a fully restored, safe environment for Maryland residents.
Prime Restoration is centrally located in Charles County, positioning them perfectly to provide fast, efficient service throughout Southern Maryland and beyond. Their facility is easily accessible, ensuring that all clients and vendors can coordinate effectively.
The operational headquarters is located at:
26 Industrial Park Dr, Waldorf, MD 20602, USA
This Waldorf location allows their emergency teams to quickly reach properties affected by a **Broken Pipe** or a severe **Storm Damage** event. A hallmark of their operation is their preparedness for immediate action. The company is set up to provide **Onsite services**, ensuring technicians are dispatched swiftly when a crisis occurs.
In terms of physical accessibility, Prime prioritizes client comfort:
- They offer a **Wheelchair accessible entrance**, making in-person consultations straightforward.
- The premises also feature a **Wheelchair accessible parking lot**.
Prime Restoration’s service portfolio is extremely comprehensive, covering the entire spectrum of disaster recovery, environmental remediation, and reconstruction. They simplify the complex process by offering all necessary services under one roof.
- 24/7 Emergency and Mitigation Services: Includes immediate response for **Emergency Water Extraction**, **Repair Emergency**, cleanup for **Burst Pipes** and **frozen pipe burst water damage cleanup**, **Roof Tarp And Board Up**, and rapid **Water Removal**.
- Water Damage and Structural Drying: Expert services covering all aspects of water recovery, such as **Water Damage Cleanup**, **Drying And Dehumidification**, **Structural Drying**, and **Ceiling Water Damage Repair**.
- Mold Inspection and Remediation: A highly specialized area including **Mold Inspection and Remediation**, **Mold Testing**, **Black Mold Removal**, **Mold Damage Cleanup**, **Mold Odor Removal**, and addressing **Emergencies Mold Damage**.
- Fire and Smoke Damage Restoration: Complete service for properties affected by fire, including **Fire Damage Restoration**, **Fire Restoration**, **Smoke Damage Cleanup**, and **Soot Removal**.
- General Cleaning and Environmental: Specialized cleaning services like **Sewage Backup Cleaning**, **Air Duct Cleaning**, **Air Scrubbing**, **Disinfection**, **Asbestos Removal**, **Hoarding Cleaning**, and deep cleaning of textiles via **Carpet & Upholstery Cleaning** and **Hard Surface Cleaning**.
- Structural Repair and Reconstruction: Full contractor services including **Structural Damage** repair, **Structural Stabilization And Repair**, **Reconstruction**, and **Complete Reconstruction** to return the property to pre-disaster state.
- Rebuilding and Remodeling: Beyond restoration, they offer high-quality finishing work such as **Home Remodeling**, **Bathroom Remodeling**, **Flooring**, **Painting**, **Roofing**, **Kitchen Cabinet** repair, and general **Home Maintenance**.
- Contents Management and Restoration: Specialized services to salvage belongings, including **Content Pack Out**, **Content Cleaning**, **Furniture Restoration**, **Document Drying**, and **Furniture Repair**.
Prime Restoration stands out in the Southern Maryland market due to its commitment to full-spectrum service and highly specialized expertise.
- Total Restoration Authority: They are masters of the entire restoration cycle, offering everything from **Emergency Cleanup** and certified **Asbestos Removal** all the way through to final **Remodeling** and **Complete Reconstruction**. This means Maryland property owners only need one company to manage a complex disaster.
- Focus on Health and Safety: Their commitment extends to ensuring a healthy living environment, demonstrated by their extensive services in **Mold Remediation Services**, **Black Mold** removal, **Air Scrubbing**, and thorough **Disinfection** following water or sewage incidents. They don’t just dry; they ensure the space is safe.
- 24/7 Emergency Readiness: The ability to mobilize instantly for **Emergencies Mold Damage** or a **Burst Pipes** scenario is crucial in limiting damage. Their **Repair Emergency** focus gives Maryland clients peace of mind that help is available immediately, day or night.
- High-Quality Final Finish: Unlike many mitigation-only firms, Prime's expertise as a general contractor allows them to complete reconstruction with a focus on quality finishes, including **Flooring**, **Painting**, and full **Bathroom Remodeling**, ensuring the repaired space often looks better than before the damage occurred.
- Comprehensive Inspection and Documentation: Services like **Damage Inspection** and **Mold Assessment** are key for a smooth process, especially when dealing with insurance claims. They are equipped to thoroughly document the damage and remediation efforts.
If you are a property owner in Waldorf or the surrounding Southern Maryland area and require urgent disaster recovery or specialized restoration services, you can contact Prime Restoration directly.
Address: 26 Industrial Park Dr, Waldorf, MD 20602, USA
Phone: (301) 848-4499
Mobile Phone: +1 301-848-4499
When facing a devastating situation like fire, water, or severe mold damage, what Maryland property owners need most is a single point of responsibility and a guarantee of expertise—which is exactly what Prime Restoration offers. It is worth choosing them because their spectrum of service is unparalleled, efficiently merging emergency mitigation with expert **Home Remodeling** capabilities.
For the Southern Maryland community, the presence of dangerous substances like **Asbestos Removal** and the persistent threat of **Black Mold** after a water event are serious concerns. Prime not only removes the water but also handles the high-stakes environmental hazards with professional certification, offering a complete health and safety package. The feedback from real customers highlights both the urgent, professional speed of their response—"They were at our home within an hour"—and the depth of their reconstruction skills—making the basement look "better than before the damage." Their team's ability to act as a **Water Restoration Mold Remediation** expert while seamlessly transitioning into a full-scale general contractor for the final rebuild sets them apart. They provide the ultimate relief: the peace of mind that one expert team will manage the entire journey, from a simple **Roof Repair** after a storm to a full **Complete Reconstruction**, allowing the client to focus on their life while Prime focuses on the restoration.
Prime Services
Water Damage Restoration Service
- Flooring
We provide water damage restoration services to remove flooding and excess water from homes and buildings.
- Painting
- Remodeling
We provide reconstruction services to stabilize and repair heavily damaged homes and buildings. Our technicians can provide complete reconstruction to repair severe structural damage as well as damage to the inter
- Roofing
- Air Duct Cleaning
We provide Air Duct Cleaning services. We will thoroughly remove dust and dirt buildup from the air ducts and component parts.
- Air Scrubbing
At Prime Restoration, we provide Air Scrubbing Services. An air scrubber is a device that attaches directly to the ductwork of your HVAC system.
- Asbestos Removal
Prime Restoration provides asbestos removal services in Waldorf and Bennsville, MD. Our technicians will safely remove all asbestos from your property.
- Bathroom Remodeling
- Battery Backup Sump Pump
We provide Battery Backup Sump Pump repair services to remove flooding and excess water from homes and buildings. Our technicians use advanced extraction and dehumidification equipment to dry the property and we will restore the resulting damage.
- Black Mold
We provide Black Mold remediation services to remove mold growth from homes and businesses. Our professionals will isolate and remove all mold growth to ensure that your property is mold free.
- Black Mold Removal
We provide Black Mold Removal services to remove mold growth from homes and businesses. Our professionals will isolate and remove all mold growth to ensure that your property is mold free.
- Broken Pipe
Prime Restoration provides water damage restoration services in Waldorf and Bennsville, MD to remove flooding and excess water from homes and buildings.
- Burst Pipes
We provide water damage restoration services after Burst Pipes to remove flooding and excess water from homes and buildings. Our technicians use advanced extraction and dehumidification equipment to dry the property and we will restore the resulting damage.
- Carpet & Upholstery Cleaning
- Ceiling Water Damage Repair
We provide Ceiling Water Damage Repair services to remove flooding and excess water from homes and buildings. Our technicians use advanced extraction and dehumidification equipment to dry the property and we will restore the resulting damage.
- Commercial Cleaning Services
- Commercial Mold Remediation Cleaning
We provide Commercial Mold Remediation Cleaning to remove mold growth from homes and businesses. Our professionals will isolate and remove all mold growth to ensure that your property is mold free.
- Complete Reconstruction
At Prime Restoration, we provide reconstruction services to stabilize and repair heavily damaged homes and buildings. Our technicians can provide complete reconstruction to repair severe structural damage as well as damage to the interior and exterior of a building.
- Content Cleaning
- Content Pack Out
- Damage Inspection
- Disinfection
- Document Drying
At Prime Restoration, we can help salvage your damaged personal items after a disaster with our content cleaning services in Waldorf and Bennsville, MD.
- Drying And Dehumidification
- Emergencies Mold Damage
We provide Emergencies Mold Damage remediation services to remove mold growth from homes and businesses. Our professionals will isolate and remove all mold growth to ensure that your property is mold free.
- Emergency Cleanup
Our entire team at Prime Restoration from our technicians is committed to providing the best possible Emergency Cleanup to help homeowners and business owners in their time of need.
- Emergency Water Extraction
- Fire Damage Restoration
- Fire Restoration
We provide fire damage restoration services to help homes and businesses to recover from a fire. Our highly skilled technicians use hi-tech restoration methods and equipment to restore structural fire damage and get rid of smoke and soot.
- Full Restoration To Pre Disaster Conditions
- Furniture Repair
- Furniture Restoration
- Hard Surface Cleaning
- Hoarding Cleaning
Prime Restoration provides hoarding cleaning services in Waldorf and Bennsville, MD to help restore hoarded homes to safe conditions.
- Home Maintenance
Our entire team at Prime Restoration from our technicians is committed to providing the best possible Home Maintenance to help homeowners and business owners in their time of need.
- Home Remodeling
- Home Restoration
We provide Home Restoration. Each of our technicians is highly trained and uses the best methods and equipment available to ensure quality results.
- Kitchen Cabinet
- Mold Assessment
- Mold Cleaning
- Mold Damage Cleanup
We provide Mold Damage Cleanup services to remove mold growth from homes and businesses. Our professionals will isolate and remove all mold growth to ensure that your property is mold free.
- Mold Inspection
- Mold Inspection and Remediation
We provide Mold Inspection and Remediation services to remove mold growth from homes and businesses. Our professionals will isolate and remove all mold growth to ensure that your property is mold free.
- Mold Odor Removal
- Mold Remediation Cleaning
We provide Mold Remediation Cleaning services to remove mold growth from homes and businesses. Our professionals will isolate and remove all mold growth to ensure that your property is mold free.
- Mold Remediation Services
- Mold Removal And Remediation
We provide Mold Removal And Remediation services to remove mold growth from homes and businesses. Our professionals will isolate and remove all mold growth to ensure that your property is mold free.
- Mold Removal and Deodorization
We provide Mold Removal and Deodorization services to remove mold growth from homes and businesses. Our professionals will isolate and remove all mold growth to ensure that your property is mold free.
- Mold Testing
- Power Washing
At Prime Restoration, we provide soft wash roof cleaning services in Waldorf and Bennsville, MD to safely and effectively clean residential roofing.
- Reconstruction
- Repair Emergency
You can count on our highly trained and insured technicians to know exactly how to respond to any type of disaster and take the right steps to restore the damage to your property.
- Roof Repair
- Roof Tarp And Board Up
- Sewage Backup Cleaning
We provide Sewage Backup Cleaning services to remove flooding and excess water from homes and buildings. Our technicians use advanced extraction and dehumidification equipment to dry the property and we will restore the resulting damage.
- Smoke Damage Cleanup
- Soot Removal
- Storm Damage
Each of our technicians is highly trained and uses the best methods and equipment available to ensure quality results. When you call us in the aftermath of a disaster, our top priorities are expertise, quality, and friendly service as we help you recover.
- Structural Damage
Each of our technicians is highly trained and uses the best methods and equipment available to ensure quality results. When you call us in the aftermath of a disaster, our top priorities are expertise, quality, and friendly service as we help you recover.
- Structural Drying
Prime Restoration provides water damage restoration services in Waldorf and Bennsville, MD to remove flooding and excess water from homes and buildings.
- Structural Stabilization And Repair
- Tile & Grout Cleaning
Here at Prime Restoration, we fully sanitize and restore tile and grout surfaces for homes and businesses in Waldorf and Bennsville, MD and leave these surfaces in their original condition.
- Upholstery Cleaning
- Wall And Hvac Cleaning
- Water Damage Cleanup
- Water Removal
- Water Restoration Mold Remediation
We provide Water Restoration Mold Remediation services to remove mold growth from homes and businesses. Our professionals will isolate and remove all mold growth to ensure that your property is mold free.
- frozen pipe burst water damage cleanup
One prevalent winter concern in snowy weather is frozen pipes, which can burst and result in water damage. We are equipped to handle all emergencies. They promptly arrive at your property, remove the water and restore the home to a safe living condition.
Prime Details
Service options
- Onsite services
- Online estimates
Accessibility
- Wheelchair accessible entrance
- Wheelchair accessible parking lot
Prime Location
Prime
26 Industrial Park Dr, Waldorf, MD 20602, USA
Prime Reviews
insurance companycommunicationprojectjobstarmanagement2024drywallcontractorbasement
★ 5★ 4★ 3★ 2★ 1DO NOT USE THIS COMPANY!I was sent to them thru my insurance company. Not only are they IMPOSSIBLE to get on the phone and get something scheduled. I was told I had to pay out of pocket for something that they messed up and was only told a day into my project. It had been scheduled for 4 months, they had plenty of time to alert someone.Then the owner just gaslighted me “I’m the owner and heard about what was happening and I’m gonna make it right” and didn’t do anything. The only reason I didn’t have to pay out of pocket, is because we wouldn’t allow them to complete our project.
Sep 19, 2025 · Jennifer StanfieldFrom the moment I called Prime Restoration, I felt like I was in good hands. We had a major water leak in our basement, and they were at our home within an hour. The crew was professional, fast, and respectful of our space. They handled the water extraction, drying, and even helped coordinate with our insurance company so we didn’t have to deal with the back-and-forth.Their team went above and beyond — they found hidden mold behind the drywall we never would have noticed, explained the remediation process clearly, and made sure the air quality was tested and safe before leaving. Communication was great throughout the job, and the reconstruction they did afterward made our basement look better than before the damage.If you’re dealing with water damage, mold issues, or just need a team that truly cares, I can’t recommend Prime Restoration enough. You don’t find customer service like this anymore — 10/10.
Jun 17, 2025 · Val R.Super grateful for Prime Restoration! They showed up fast after we had a leak and got everything under control way quicker than I expected. Everyone I talked to was helpful and actually explained what was going on instead of just rushing through it. No stress, no runaround just solid work. Would definitely call them again if I ever needed to.
Jun 17, 2025 · Axel SmithHuge thank you to Prime Restoration for their amazing customer service and thorough air duct and dryer vent cleaning! The team was professional, and explained everything clearly to me and my husband. I can already tell the air quality has improved, as have my allergies. Highly recommend!
Jun 06, 2025 · SarahPrime did a wonderful job on a water mitigation at our home. Advising each step of the way as to why they were proceeding with the demo and equipment. Great communication and polite employees. I would highly recommend them.
Jun 03, 2025 · Dawn Pratt
More Water Damage Restoration Near Me
 Scope, Inc4.0 (81 reviews)
Scope, Inc4.0 (81 reviews)6 Irongate Dr, Waldorf, MD 20602, USA
 Ready 2 Remodel5.0 (90 reviews)
Ready 2 Remodel5.0 (90 reviews)3261 Old Washington Rd Suite 2020, Waldorf, MD 20602, USA
 SERVPRO of Charles County4.0 (107 reviews)
SERVPRO of Charles County4.0 (107 reviews)4441 Southern Business Park Dr, White Plains, MD 20695, USA
 Jenkins Restoration and Remodel4.0 (65 reviews)
Jenkins Restoration and Remodel4.0 (65 reviews)8352 Old Leonardtown Rd, Hughesville, MD 20637, USA
 C & C Complete Services4.0 (22 reviews)
C & C Complete Services4.0 (22 reviews)7327 Old Alexandria Ferry Rd, Clinton, MD 20735, USA
 TBC Servs4.0 (100 reviews)
TBC Servs4.0 (100 reviews)29270 Three Notch Rd, Mechanicsville, MD 20659, USA
 ServiceMaster National Capital Restoration4.0 (184 reviews)
ServiceMaster National Capital Restoration4.0 (184 reviews)7551 Fordson Rd, Alexandria, VA 22306, USA
 1800 Packouts of DMV5.0 (1 reviews)
1800 Packouts of DMV5.0 (1 reviews)4901 Beech Pl suite b, Temple Hills, MD 20748, USA
 Benko Disaster Restoration5.0 (13 reviews)
Benko Disaster Restoration5.0 (13 reviews)10816 Town Center Blvd, Dunkirk, MD 20754, USA
 SERVPRO of Calvert County5.0 (40 reviews)
SERVPRO of Calvert County5.0 (40 reviews)4130 Old Town Rd, Huntingtown, MD 20639, USA
 Bay View4.0 (52 reviews)
Bay View4.0 (52 reviews)2800 Eisenhower Ave Suite 220, Alexandria, VA 22314, USA
 CRM Construction Inc.4.0 (23 reviews)
CRM Construction Inc.4.0 (23 reviews)1355 Skinners Turn Rd, Owings, MD 20736, USA
Categories
Top Visited Sites
 OMG Sanitized, Inc.5.0 (37 reviews)
OMG Sanitized, Inc.5.0 (37 reviews) SERVPRO of South Shreveport, Bossier4.0 (212 reviews)
SERVPRO of South Shreveport, Bossier4.0 (212 reviews) Recon Restorations4.0 (76 reviews)
Recon Restorations4.0 (76 reviews) Water Damage Guy5.0 (1 reviews)
Water Damage Guy5.0 (1 reviews) Sunshine Restoration Group4.0 (141 reviews)
Sunshine Restoration Group4.0 (141 reviews) Kefficient5.0 (437 reviews)
Kefficient5.0 (437 reviews)Top Searches
Trending Damage Repair Guides Posts
 Water Damage Repair for Subflooring Under Carpets
Water Damage Repair for Subflooring Under Carpets How to Handle Water Damage After a Storm: A Step-by-Step Guide
How to Handle Water Damage After a Storm: A Step-by-Step Guide Water Damage Restoration for Restaurants and Food Service Areas – A Complete Guide
Water Damage Restoration for Restaurants and Food Service Areas – A Complete Guide How to Deal With Water Damage From Roof Ice Dams: Prevention and Repair Tips
How to Deal With Water Damage From Roof Ice Dams: Prevention and Repair Tips What to Do if Your Roof Is Leaking and Causing Water Damage Inside
What to Do if Your Roof Is Leaking and Causing Water Damage Inside How to Restore Water-Damaged Rugs and Carpets
How to Restore Water-Damaged Rugs and Carpets